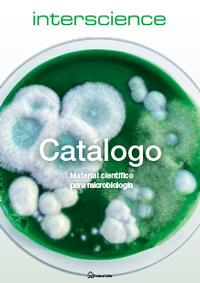

Productos
Servicios
Servicios
Área privada (tienda on-line)
B2B - Proveedor global
Plataformas de compra (punch-outs)
Hecho a medida
Productos OEM
Servicio de envases retornables
Servicios en cromatografía
Servicios en microbiología
Servicios en vidrio
Servicio técnico
Servicio de amortizaciones por consumo
Gestión de inventarios S-LIM
Servicio de entregas
Reclamaciones de calidad
Devolución de producto
Servicios Outsourcing
Promociones
Promociones
Promoción Velp. Nuevos termorreactores ECODryBlock
Promoción Velp. Serie Advance. Nuevas placas calefactoras con agitación
Promoción Scharlau by Afora: Componente Schlenk Universal y Aparato Dean-Stark Multicolector
Promoción Control de Legionella 2026 | Medios, Cepas y Material ISO 11731
Promoción DWK Duran®: vasos de precipitados y matraces Erlenmeyer
Promoción PIPETMAN® L de Gilson – Starter Kits y Puntas con 25% de Descuento | Scharlab España
Promoción tapas de silicona DURAN®: solución flexible para laboratorio
Promoción IKA 2026: Soluciones innovadoras para laboratorio
Promoción balanzas Sartorius ENTRIS II, SECURA y QUINTIX 2026
Jarras de alúmina para molino rápido: Promoción 3×2 para laboratorios cerámicos
Promoción equipos Gerhardt con servicio técnico oficial: Instalación y mantenimiento gratis
Promoción equipos Nannetti para laboratorio cerámico y control de materiales 2026
Promoción lanzamiento. Nuevos baños termostáticos Universa de Lauda

 España
España